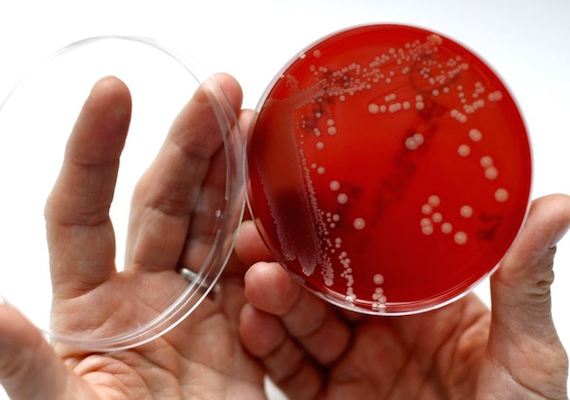

An international team of scientists has identified a new kind of “superbug” -- or strong bacteria -- that has made people sick. They link the development of the superbug to the use of antibiotic drugs in farm animals. The scientists say this new strain of Methicillin-resistant Staphylococcus aureus -- known as MRSA sickened at least 10 people in Denmark. They said the bacteria is resistant to several antibiotics and can kill chickens. This strain is not found in Denmark. The researchers believe the Danes likely got sick from it by eating or being close to imported chicken. Most people do not get MRSA from animals used as food. The bacteria usually spreads through person-to-person contact in hospitals or other buildings where people live in small, crowded spaces. Farm workers have a higher risk of staph infections. The researchers compared the strains of MRSA in the 10 Danes to staph infections in other people and in livestock. They found the strain came from poultry.
Title: "Superbug" Linked to Chicken Sickens People
Content: <div id='article-page'><div id='article-content' data-media-url='//news-app-staging.s3.amazonaws.com' data-base-url='//news-app-staging.herokuapp.com' data-sound-name='https://news-app-production.s3.amazonaws.com/articles/1413/chicken_superbug.m4a' data-capture-url='//staging.analytics.lingraphica.com/events/capture_news' data-article-title='"Superbug" Linked to Chicken Sickens People' data-article-id='1911'><script src='//news-app-staging.herokuapp.com/javascripts/getscripts.js'></script><link rel='stylesheet' href='//news-app-staging.herokuapp.com/stylesheets/article.css' type='text/css' /><div class='article'><p><span data-start-time='0' data-end-time='11125'>An international team of scientists has identified a new kind of “superbug” -- or strong bacteria -- that has made people sick.</span> <span data-start-time='11125' data-end-time='19438'>They link the development of the superbug to the use of antibiotic drugs in farm animals.</span> <span data-start-time='19438' data-end-time='33896'>The scientists say this new strain of Methicillin-resistant Staphylococcus aureus -- known as MRSA sickened at least 10 people in Denmark.</span> <span data-start-time='33896' data-end-time='42500'>They said the bacteria is resistant to several antibiotics and can kill chickens.</span> <span data-start-time='42500' data-end-time='46938'>This strain is not found in Denmark.</span> <span data-start-time='46938' data-end-time='55875'>The researchers believe the Danes likely got sick from it by eating or being close to imported chicken.</span> <span data-start-time='55875' data-end-time='62313'>Most people do not get MRSA from animals used as food.</span> <span data-start-time='62313' data-end-time='75021'>The bacteria usually spreads through person-to-person contact in hospitals or other buildings where people live in small, crowded spaces.</span> <span data-start-time='75021' data-end-time='80604'>Farm workers have a higher risk of staph infections.</span> <span data-start-time='80604' data-end-time='91792'>The researchers compared the strains of MRSA in the 10 Danes to staph infections in other people and in livestock.</span> <span data-start-time='91792' data-end-time='95396'>They found the strain came from poultry.</span> </p></div><div class='control-buttons-sticky' style='display:none;'><div class='control-buttons'><button title='Back' class='back' disabled='disabled'></button><button title='Play' class='play' disabled='disabled'></button><button title='Pause' class='pause' style='display:none;'></button><button title='Forward' class='forward' disabled='disabled'></button><button class='finished-reading' style='display:none;'>Done</button></div></div></div><div id='article-media'><div id='media-image'><img src='https://news-app-production.s3.amazonaws.com/articles/1413/chicken_superbug.jpg'/></div></div><div id='question-content' style='display:none;'><div class='vocabulary_question question-container' data-question-id=7309 data-hint-location='19438' style='display:none;'><div class='question' data-sound-name='https://news-app-production.s3.amazonaws.com/articles/1413/what_does_strain_mean.m4a'>What does strain mean?</div><div class='choices' data-correct-choice='one of several closely related infectious micro-organisms'><div class='choice' data-sound-name='https://news-app-production.s3.amazonaws.com/articles/1413/one_of_several_closely_related_infectious_microorganisms.m4a'><span>one of several closely related infectious micro-organisms</span></div><div class='choice' data-sound-name='https://news-app-production.s3.amazonaws.com/articles/1413/something_that_is_not_harmful_to_humans.m4a'><span>something that is not harmful to humans</span></div><div class='choice' data-sound-name='https://news-app-production.s3.amazonaws.com/articles/1413/a_type_of_medicine.m4a'><span>a type of medicine</span></div><div class='choice' data-sound-name='https://news-app-production.s3.amazonaws.com/articles/1413/something_that_cures_disease.m4a'><span>something that cures disease</span></div></div></div><div class='multiple_choice_question question-container' data-question-id=7310 data-hint-location='46938' style='display:none;'><div class='question' data-sound-name='https://news-app-production.s3.amazonaws.com/articles/1413/what_type_of_animal_made_people_sick_in_denmark.m4a'>What type of animal made people sick in Denmark?</div><div class='choices' data-correct-choice='Chicken'><div class='choice' data-sound-name='https://news-app-production.s3.amazonaws.com/articles/1413/chicken.m4a'><span>Chicken</span></div><div class='choice' data-sound-name='https://news-app-production.s3.amazonaws.com/articles/1413/rabbit_.m4a'><span>Rabbit </span></div><div class='choice' data-sound-name='https://news-app-production.s3.amazonaws.com/articles/1413/duck.m4a'><span>Duck</span></div><div class='choice' data-sound-name='https://news-app-production.s3.amazonaws.com/articles/1413/cow.m4a'><span>Cow</span></div></div></div><div class='sentence_completion_question question-container' data-question-id=7311 data-hint-location='75021' style='display:none;'><div class='question' data-sound-name='https://news-app-production.s3.amazonaws.com/articles/1413/_blank__workers_have_a_higher_risk_of_staph_infections.m4a'><span class='blank'>Farm</span> workers have a higher risk of staph infections.</div><div class='choices' data-correct-choice='Farm'><div class='choice' data-sound-name='https://news-app-production.s3.amazonaws.com/articles/1413/sewage.m4a'><span>Sewage</span></div><div class='choice' data-sound-name='https://news-app-production.s3.amazonaws.com/articles/1413/office.m4a'><span>Office</span></div><div class='choice' data-sound-name='https://news-app-production.s3.amazonaws.com/articles/1413/construction.m4a'><span>Construction</span></div><div class='choice' data-sound-name='https://news-app-production.s3.amazonaws.com/articles/1413/farm.m4a'><span>Farm</span></div></div></div><div class='question-buttons'><button class='skip-button'></button><button class='hint-button'></button><button class='speak-button'></button></div></div></div>
Sound Name: https://news-app-production.s3.amazonaws.com/articles/1413/chicken_superbug.m4a
Preview